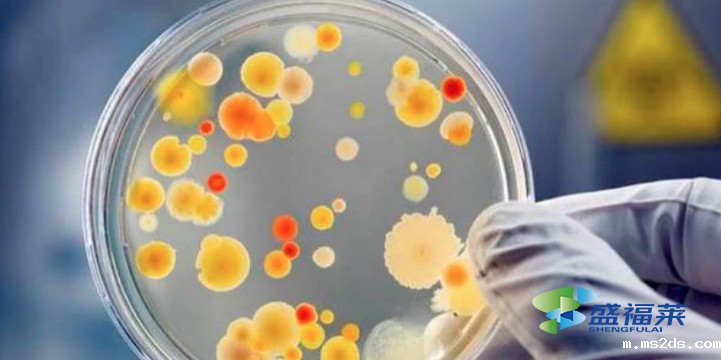
碳源的种类及碳源在污水处理中的作用

咨询热线13140097958
生物碳源与复合碳源是两种在污水处理、土壤改良及其它环境修复工程中常用的碳源类型。生物碳源和复合碳源在来源、组成、用途···

在污水处理过程中,碳源的选择和使用是至关重要的。选择合适的碳源,并正确使用可以提高污水处理效率,降低成本,减少环境污···

复合碳源含有效COD含量高,针对反硝化细菌专一定制的含糖类物质,性价比普遍优于甲醇、乙醇、淀粉、 葡萄糖、乙···

新型复合碳源是由各种复合糖不完全酸水解或不完全酶水解制成的。有效COD含量高,易被微生物吸收,可缩短驯化···

新型复合碳源由多种有机氨基酸组成,用量少,能起到快速细菌培养的作用,使用后水质相对稳定。复合碳源是一···

目前市面上常用的碳源:甲醇、乙酸、乙酸钠、面粉、葡萄糖、生物质碳源、污泥水解上清液、啤酒废水及垃圾渗滤液等···
复合碳源主要用于污水处理,可将其添加到污水处理的中介罐中,以提高反应速度和提高COD,BOD等参数的效果。复合碳源···

当污水处理厂生化系统进水碳源明显不足时,需要添加碳源。碳源的选择非常重要。除了使用固体碳源的小规模系统外,目前大多数系···

污水处理一般采用复合碳源,是为了更好的培养细菌,提高污水的可生化性,有效提高污泥的亲和性,优于尿素。复合碳源中的···
